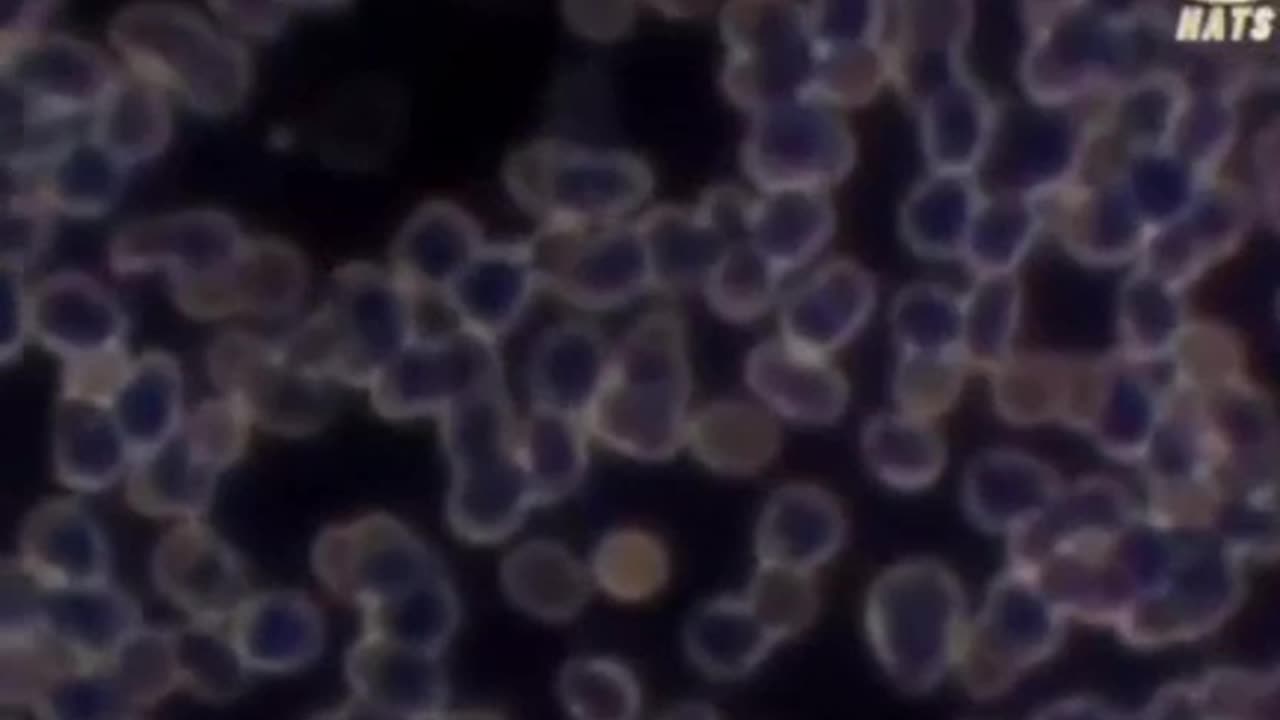

Premium Only Content
This video is only available to Rumble Premium subscribers. Subscribe to
enjoy exclusive content and ad-free viewing.
November 26, 2023
Loading comments...
-
LIVE
SpartakusLIVE
6 hours ago$120,000 WZ Tourney || #1 Tournament Champion RETURNS
132 watching -
47:47
Athlete & Artist Show
6 hours ago $0.51 earnedSeason 6 Premiere, NHL Season Preview!
7.03K2 -
17:17
Advanced Level Diagnostics
19 days ago $0.36 earnedWhy won't this Mack Truck Charge!
5.06K1 -
1:33:51
Steve-O's Wild Ride! Podcast
16 days ago $11.53 earnedJohn C. Reilly's Surprising Connection To Jackass (And Beef With Weeman!)
105K21 -
LIVE
StoneMountain64
3 hours agoBattlefield 6 Unlocks and Challenges
94 watching -
LIVE
Total Horse Channel
11 hours agoLow Roller Reining Classic | Main Arena | October 11th, 2025
157 watching -
LIVE
GamerGril
3 hours agoZombie Fight Club 💞Dying Light The Beast💞
111 watching -
56:25
MentourPilot
1 year agoTITANIC of the Skies! - The Untold Story of Air France 447
35.8K7 -
LIVE
Lofi Girl
2 years agoSynthwave Radio 🌌 - beats to chill/game to
259 watching -
2:07:47
LFA TV
18 hours agoTHE RUMBLE RUNDOWN LIVE @9AM EST
84.7K14